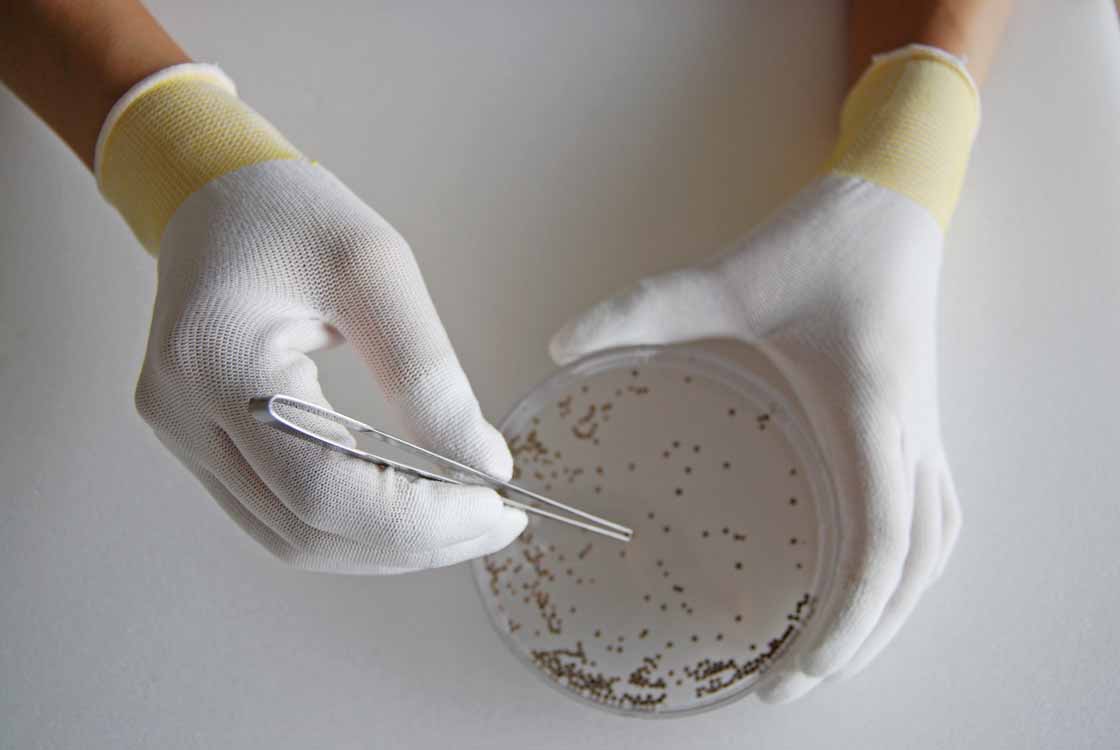
イメージ画像（トップフィット）

小さな部品もしっかりキャッチ
指先に発泡ポリウレタンをコーティングしているため、スベリ止め効果を発揮します。

優れたフィット感
手によくフィットするため、指が動かしやすく細かな作業に適しています。

転写対策に
手袋を製造する過程で、潤滑油などが残留していると、
手袋表面からの溶出物(油分など)が転写し製品不良の原因となることがあります。
繊維の洗浄段階から工程管理を行うことで、残留溶出物を抑えています。

発塵対策に
ホコリの発生しにくい長繊維を採用しています。

特 長
● 発泡ポリウレタンを指先にコーティングしているため、高いスベリ止め効果を発揮し、通気性にも優れています。
● 繊維部分は編み目が細かく縫い合わせのない、独自の13ゲージ・シームレス編み手袋です。
● 長繊維を採用しているため、手袋からのホコリや糸くずの発生を抑えます。
● 裾部分は、ほつれを防ぐオーバーロック加工を施しています。
● 左右兼用タイプです。
● 繊維部分は編み目が細かく縫い合わせのない、独自の13ゲージ・シームレス編み手袋です。
● 長繊維を採用しているため、手袋からのホコリや糸くずの発生を抑えます。
● 裾部分は、ほつれを防ぐオーバーロック加工を施しています。
● 左右兼用タイプです。
用 途
運輸・物流業 / 機械工業 / 精密機械工業 / 自動車関連業 など
商品仕様
-
製品情報
発泡ポリウレタン製指先コート手袋
-
素材(樹脂部)
ポリウレタン
-
素材(繊維部)
ナイロン
ポリエステル その他 -
内容量
1双
-
生産地
マレーシア
| サイズ | カラー | 製品寸法 | JANコード | |||
|---|---|---|---|---|---|---|
| 本体 | 手首 | 全長 | 手のひら まわり |
中指長さ | ||
| S | ホワイト | イエロー | 18.5 cm | 15.5 cm | 6.7 cm | 4901792960168 |
| M | ホワイト | グリーン | 19.0 cm | 17.5 cm | 7.0 cm | 4901792960175 |
| L | ホワイト | ゴールド | 20.0 cm | 18.5 cm | 7.5 cm | 4901792960182 |
使用上の注意
● アレルギー反応等により、体質によっては、かゆみ・かぶれ・発疹等をおこすことがあります。異常を感じたら使用を中止し、医師に相談してください。
● 樹脂部でも水等の液体は浸透するため、触れないでください。
● 熱いものに触れないでください。火傷するおそれがあります。
● 刃物や鋭利なものを使用する作業には充分注意してください。
● 回転体を伴う作業(ボール盤・面取り盤等)には使用しないでください。手が巻き込まれるおそれがあります。
● 感電のおそれがあるため、電気作業には使用しないでください。
● 繊維製のため、自己発塵があります。また、樹脂部においても摩耗すると発塵します。使用に際しては、発塵性を確認の上、使用してください。
● ナイロン糸を使用しているため、黄変する場合がありますが、品質には異常ありません。
● 保管する時には直射日光を避けてください。
● 樹脂部でも水等の液体は浸透するため、触れないでください。
● 熱いものに触れないでください。火傷するおそれがあります。
● 刃物や鋭利なものを使用する作業には充分注意してください。
● 回転体を伴う作業(ボール盤・面取り盤等)には使用しないでください。手が巻き込まれるおそれがあります。
● 感電のおそれがあるため、電気作業には使用しないでください。
● 繊維製のため、自己発塵があります。また、樹脂部においても摩耗すると発塵します。使用に際しては、発塵性を確認の上、使用してください。
● ナイロン糸を使用しているため、黄変する場合がありますが、品質には異常ありません。
● 保管する時には直射日光を避けてください。
-
B0500 パームフィット手袋
作業がしやすくホコリが出にくい、手にぴったりフィットする手のひらスベリ止めコーティング
-
B0610 フィット手袋 20枚入
手によくフィットし、下ばきとしても使える